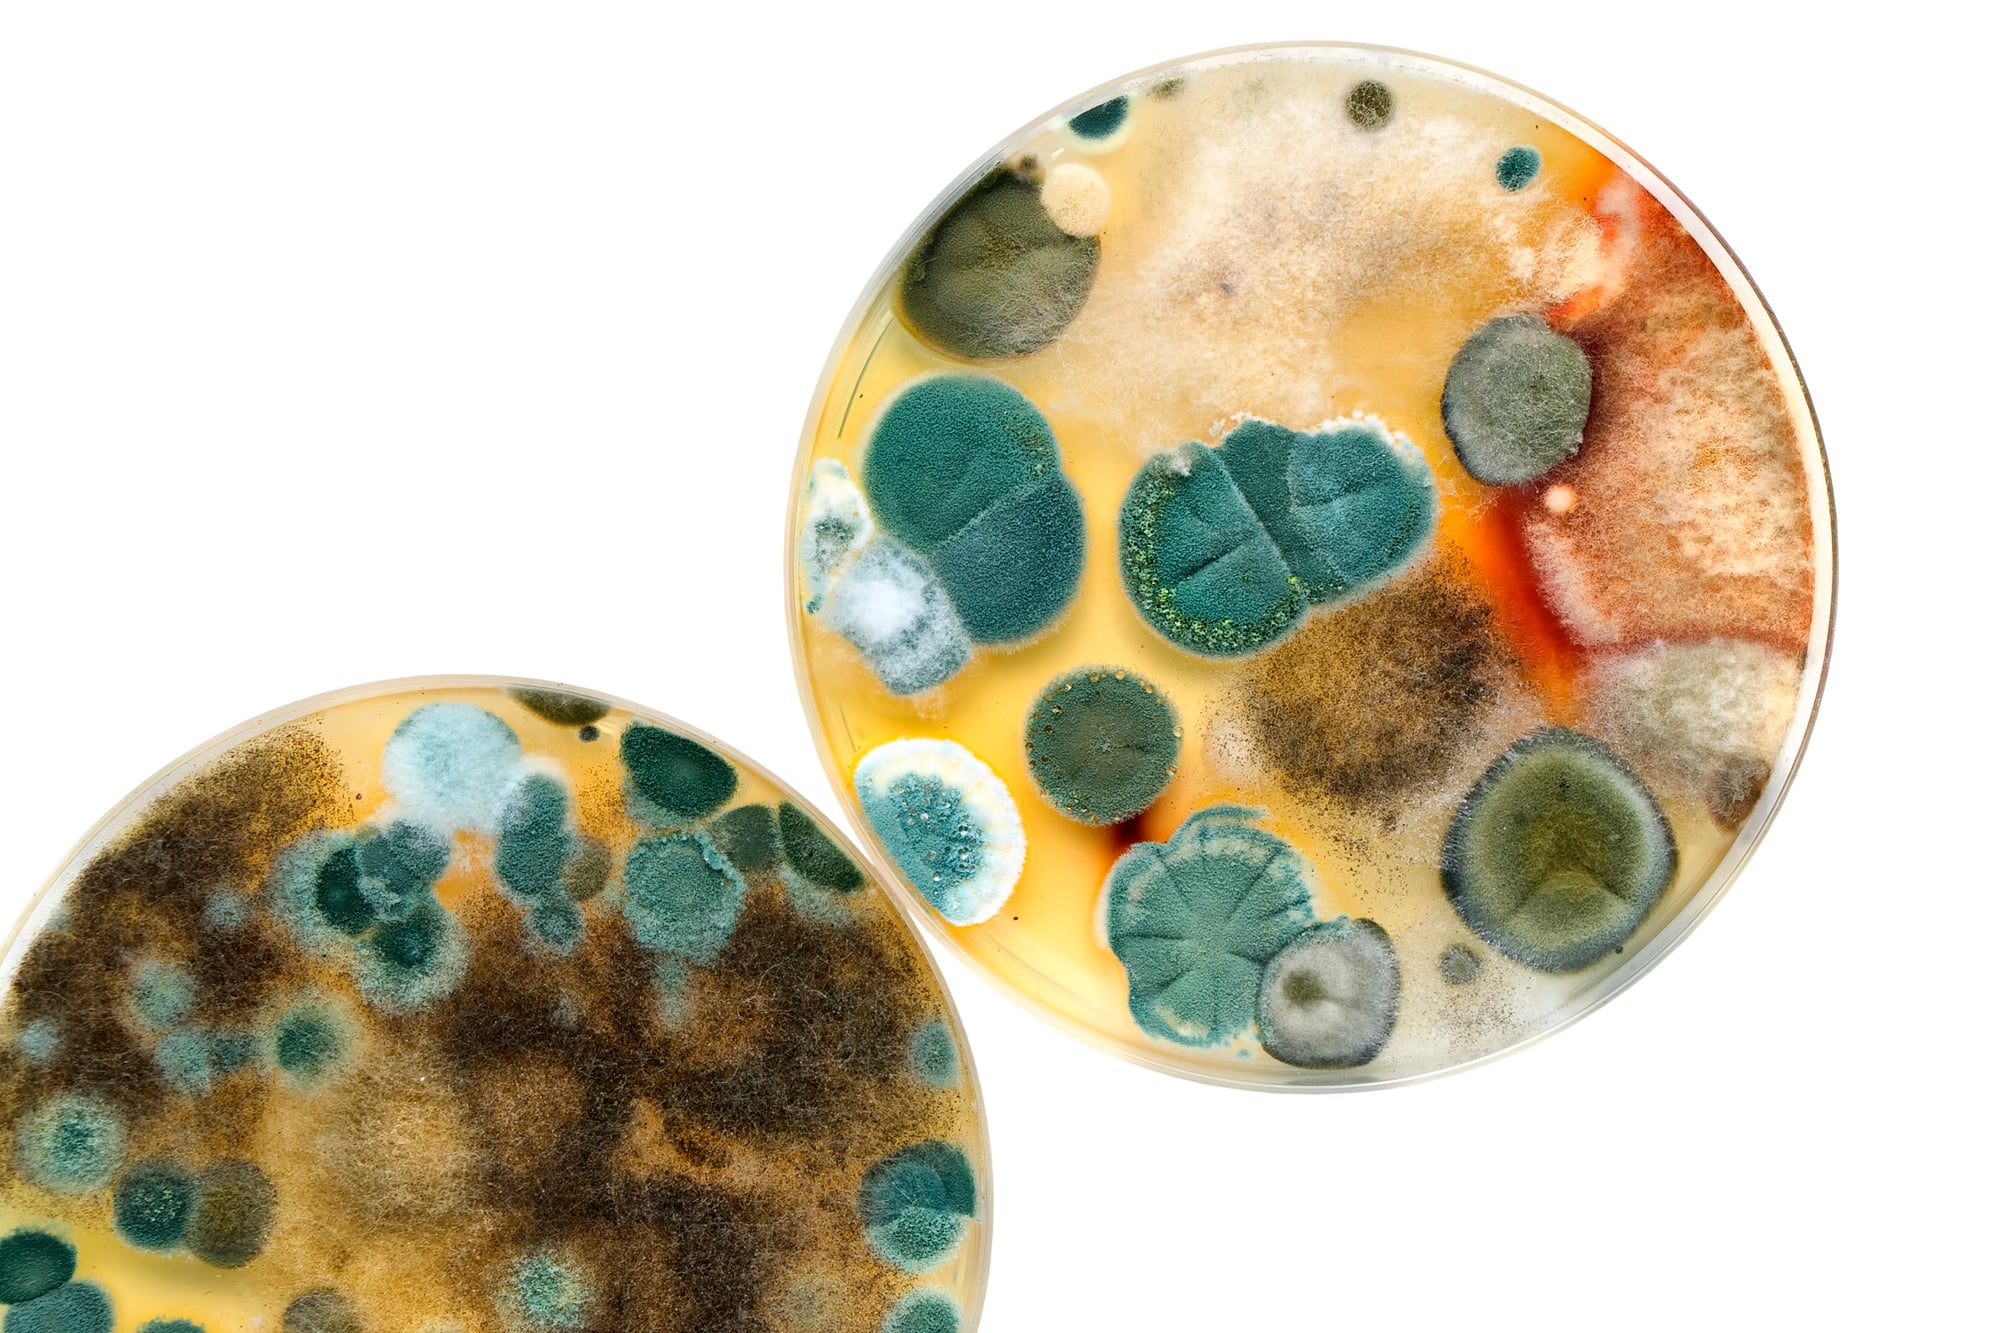

Plot Twists in Real History
History is full of surprises. Most people think the past follows a simple, straight path from one event to the next.
But the truth is messier and way more interesting. Real life has delivered moments so unexpected that they changed the course of nations, ended wars, and flipped everything people believed about their world.
These weren’t scripted moments in a movie. They actually happened, and they remind us that the real world is often stranger than fiction.
Let’s dig into some of the most jaw-dropping turns that history has taken. You might recognize a few of these, but others will probably shock you.
The man who invented dynamite wanted peace

Alfred Nobel was a Swedish engineer who made his fortune by inventing dynamite in 1867. He created the most powerful explosive the world had ever seen, and weapons makers couldn’t get enough of it.
His discovery made him rich beyond measure. But here’s where it gets wild: Nobel felt terrible about what his invention was being used for.
Wars were using his dynamite to destroy entire towns and kill thousands of people. The guilt weighed on him so heavily that he decided to use his fortune to reward people working toward peace instead of violence.
That’s why the Nobel Peace Prize exists today. The man who profited from explosions ended up creating one of the world’s greatest honors for stopping conflict.
The horse that cost an empire

In the year 1453, the Ottoman Empire decided to attack Constantinople, the capital of the Byzantine Empire. This wasn’t just any battle.
It was supposed to be the final blow against an empire that had ruled for over a thousand years. The Ottomans were well-armed, well-trained, and massively outnumbered the defenders.
For weeks, the siege wore on and looked hopeless for the Byzantines. Then something weird happened.
A horse wandered near the wall during the night. It was probably just lost or escaped from someone’s stable.
But the Ottoman soldiers thought it was a bad sign, a curse from the gods. They panicked, thinking the battle was doomed.
The defense held just long enough that day, and that single moment of confusion gave the defenders hope and time to strengthen their position. Without that random horse, history might have played out very differently.
A weather report that stopped a war

On June 6, 1944, over a million soldiers were ready to invade Normandy during World War II. The entire operation depended on good weather.
General Dwight D. Eisenhower had set the invasion date for June 5th. But a meteorologist named James Stagg looked at the weather patterns and told Eisenhower something everyone dreaded: a massive storm was coming.
Eisenhower had to make a choice that could decide the war. He delayed the invasion by one day, which seemed crazy when millions of troops were already mobilized and ready.
Stagg checked the weather again and saw a narrow window of calm weather coming on June 6th. He convinced Eisenhower to go ahead despite the risk.
The invasion succeeded partly because of Stagg’s forecast. If the general had ignored the weather expert and stuck to the original date, the operation could have been a disaster.
The accidental discovery that saved millions
In 1928, Alexander Fleming was a scientist working in a lab at St. Mary’s Hospital in London. He had been studying bacteria, and he left some petri dishes on his bench before going on vacation.
When he came back, he noticed something strange. Mold had grown on one of the dishes, and all the bacteria around the mold had died.
Most scientists would have cursed the contamination and thrown it away. But Fleming saw something different.
He realized the mold was producing a substance that killed bacteria. That substance became the first antibiotic, which we now call penicillin.
His accidental discovery has saved millions of lives from infections that would have been deadly otherwise. One messy lab and one moment of curiosity changed medicine forever.
The letter that almost started a nuclear war

During the Cold War, tensions between the United States and Soviet Union reached scary heights. On October 27, 1962, a Soviet submarine was hiding under the Atlantic Ocean during the Cuban Missile Crisis.
American destroyers were dropping explosions in the water nearby to force the submarine to surface. The Soviet captain thought World War III had started.
He gave the order to prepare a nuclear torpedo to launch at the American ships. But here’s the catch: three officers had to agree before firing a nuclear weapon.
Two of them said yes. The third officer, Vasili Arkhipov, refused to authorize the launch.
He believed the captain was making a mistake based on fear, not facts. That single act of disagreement prevented a nuclear attack that could have killed millions and sparked global war.
One man’s choice to say no changed everything.
The spy swap that nobody expected

During the Cold War, two countries rarely trusted each other enough to make deals. But in 1960, something unusual happened.
Francis Gary Powers was an American pilot flying a spy plane over Soviet territory when the Soviets shot him down. The Soviet Union captured him and held him as a prisoner.
The Americans wanted him back. Instead of using force, the CIA and Soviet intelligence decided to trade spies.
They swapped Powers for a Soviet spy named Rudolf Abel. The exchange happened at the Glienicke Bridge in Berlin.
It sounds simple, but at the time, this kind of deal was almost unthinkable between enemies. The spy swap showed that even in the coldest wars, communication and negotiation could work when both sides were desperate enough.
The king who gave up his crown for love

In 1936, King Edward VIII of England had to make an impossible choice. He was supposed to be the king and defend his country and his throne.
But he was in love with an American woman named Wallis Simpson who was divorced. At that time, divorce was considered shameful, and the British public didn’t approve.
The government, the church, and the people all told him he had to choose between love and the throne. Edward shocked everyone by choosing love.
He gave up being king, one of the most powerful positions in the world, to marry the woman he loved. His younger brother became king instead.
This decision stunned the world. A man walked away from ultimate power because of his heart, something history rarely sees.
The inventor who stole his own invention

Thomas Edison gets all the credit for inventing the lightbulb, but here’s the plot twist. A British scientist named Joseph Swan actually developed a working lightbulb before Edison did.
Swan filed for a patent in Britain first. When Edison found out, instead of competing fairly, he bought up Swan’s patent and claimed the invention as his own.
By controlling the legal rights, Edison could tell the story however he wanted. For years, Edison was known as the great inventor while Swan faded into obscurity.
It wasn’t until much later that historians uncovered what really happened. The man famous for innovation actually took credit for someone else’s work.
The disease that killed more people than warfare

World War I was one of the deadliest conflicts in history, but here’s the shocking part: more soldiers died from illness than from bullets and shells. In 1918, a flu virus spread across the world at lightning speed.
People called it the Spanish Flu, though nobody really knew where it came from. Soldiers were packed together in trenches, troop ships, and camps, making it easy for the disease to spread.
The flu killed an estimated 50 million people worldwide, more than died in the entire war. In some cases, a soldier could be healthy in the morning and dead by evening.
Governments barely talked about it because they didn’t want to admit their armies were being wiped out by an invisible enemy instead of in combat. A virus ended more lives than tanks, guns, or strategic military planning.
The scientist who proved his own theory wrong

Karl Popper was a famous philosopher of science who believed that good science means trying to prove your own ideas wrong. He spent years developing a theory about how knowledge works.
Then he did something unusual: he tested his own theory rigorously, looking for flaws. When he found the flaws, instead of covering them up, he published his findings and admitted his theory was incomplete.
Most people would have quietly moved on or tried to fix the problem in secret. Popper chose honesty.
He showed the world that his own idea didn’t hold up perfectly. His willingness to be wrong became more important to science than being right.
He proved that real genius is admitting what you don’t know.
The archaeologist who dug up a lost city by accident

In 1922, Howard Carter was searching for treasure in the Valley of the Kings in Egypt. He’d been searching for years with little success and was running out of funding.
One morning, his team found a stone step leading downward into the earth. Following it down, they discovered the tomb of Tutankhamun, a young Egyptian king.
The discovery was so important that it changed our understanding of ancient Egypt. Paintings, treasures, and artifacts from 3,000 years earlier were perfectly preserved.
Carter’s stubborn persistence had finally paid off, but it came down to pure luck and timing. If his funding had run out the week before, the tomb might have stayed buried forever.
Sometimes the biggest discoveries come when you’re almost ready to give up.
The enemy who became a friend

After World War II, Germany was devastated and occupied by other countries. Many people thought Germany would face harsh punishment and stay divided forever.
But a surprising thing happened. The Marshall Plan sent American money and resources to help rebuild Europe, including Germany.
Americans and Germans, who had just been enemies, started working together. Over time, the two countries became close allies and eventually partners in the European Union.
What seemed impossible after such a brutal war became reality through generosity and cooperation. An entire continent that had been torn apart by war slowly healed by choosing rebuilding over revenge.
The monk who saved thousands by refusing orders

During the Holocaust, Raoul Wallenberg was a Swedish diplomat living in Hungary. The Nazi government was shipping Hungarian Jews to death camps.
Most people either ignored it or cooperated. Wallenberg refused to accept the orders coming from the government.
He used his position as a diplomat to issue fake passports, hide refugees in safe houses, and put himself between soldiers and victims. He saved thousands of lives by being brave enough to say no.
Wallenberg eventually was captured and disappeared, likely killed by the Soviets. But his actions during those desperate years proved that one person with courage could matter enormously, even against impossible odds.
The treasure buried in the yard

In 1998, a person walking in their yard in Staffordshire, England found something shiny. They picked it up and realized it was gold.
Digging deeper, they discovered the Staffordshire Hoard, one of the largest collections of Anglo-Saxon gold and silver ever found. The treasure had been buried in the dirt for over 1,300 years, hiding in plain sight the entire time.
Nobody knew it was there until someone took a walk and paid attention. The discovery taught archaeologists about ancient kingdoms and cultures they barely understood before.
Sometimes history is literally waiting beneath our feet, just waiting for someone to notice it.
The radio signal that nobody understood at first

In 1967, scientists Jocelyn Bell and Antony Hewish detected a strange radio signal from space. It was regular and repeating, coming from somewhere beyond Earth.
Scientists got excited and nervous at the same time. Some thought aliens might be trying to contact us.
Others had different theories. After careful study, they realized the signals were coming from a neutron star, an object so dense that a teaspoon of its material would weigh as much as a whole mountain.
This discovery opened an entirely new field of astronomy. What seemed mysterious and even frightening turned out to be the beginning of understanding one of the universe’s strangest objects.
Scientists called these objects pulsars, and studying them changed how we see the cosmos.
The letter that changed art forever

Vincent van Gogh was a struggling artist who sold almost nothing during his lifetime. He was poor, sick, and frustrated that nobody wanted his paintings.
He lived with his brother Theo and wrote letters describing his thoughts and his dreams for his art. After van Gogh’s death, his brother Theo kept those letters and shared them with the world.
In those letters, people finally understood what van Gogh was trying to do with his bold colors and thick brushstrokes. The letters made him famous long after he was gone.
His paintings, once worthless, became some of the most valuable artworks in the world. A person nobody cared about in life became celebrated as a genius after death, thanks to words he had written in private letters.
The accident that led to modern surgery

James Young Simpson was a Scottish doctor in the 1800s who was trying to find a way to help people during surgery without causing unbearable pain. One evening, he and his colleagues were testing different chemicals to see if any could reduce pain during operations.
They breathed in some chloroform, a chemical substance, by accident. They got dizzy and passed out.
When they woke up, they realized what had just happened. Chloroform could be used to put patients to sleep during surgery so they wouldn’t feel pain.
This accidental discovery revolutionized medicine. Thousands of people would have suffered terribly during operations if Simpson hadn’t breathed in the wrong fumes at the right moment.
An accident in a lab became one of the most important medical breakthroughs in history.
Yesterday’s enemy turned today’s leader

After the Holocaust, the world faced a massive problem. How could countries rebuild and move forward after such horror?
Konrad Adenauer was a German politician who had actually opposed Hitler during the war. After the war ended, instead of seeking revenge against the enemies who had occupied Germany, he reached out to them.
He helped Germany rejoin the community of nations and apologized for the atrocities. He worked with former enemies to create a united and peaceful Europe.
His leadership showed that forgiveness and rebuilding could work better than anger and punishment. A man who could have demanded justice instead chose to build bridges, and that choice shaped the modern world.
Time folds back on itself

The past keeps surprising us because history isn’t as simple as we thought it was. The people who lived through these moments were just ordinary humans dealing with extraordinary situations.
They didn’t always have a master plan. Sometimes they won through luck, other times through courage, and occasionally through simple stubbornness.
What’s clear is that tiny moments, random accidents, and unexpected choices added up to create the world we live in today. Understanding these turns in the road helps us see that the future isn’t written either.
The choices people make today, no matter how small they seem, might become the plot twists that future generations will study and marvel at.
More from Go2Tutors!

- The Romanov Crown Jewels and Their Tragic Fate
- 13 Historical Mysteries That Science Still Can’t Solve
- Famous Hoaxes That Fooled the World for Years
- 15 Child Stars with Tragic Adult Lives
- 16 Famous Jewelry Pieces in History
Like Go2Tutors’s content? Follow us on MSN.